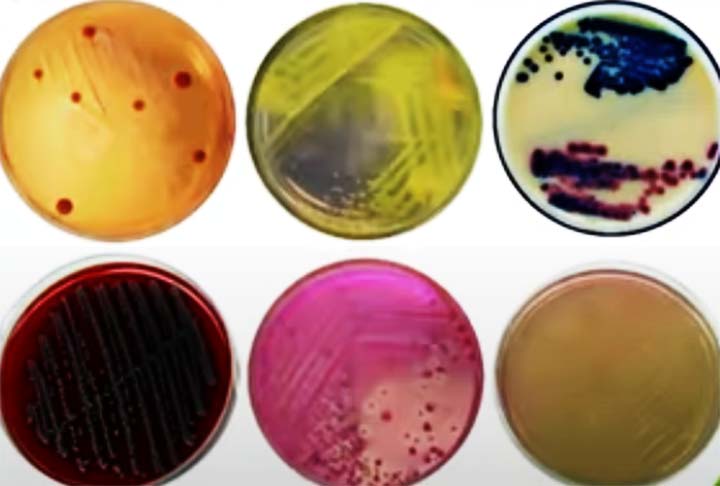
Koch também desenvolveu métodos e técnicas laboratoriais, como a cultura de bactérias em meios sólidos e o uso de corantes para a visualização microscópica de microrganismos, que são práticas padrão até hoje

Expoentes da Biologia: gênios que fizeram descobertas para a Ciência

Os cookies nos ajudam a administrar este site. Ao usar nosso site, você concorda com nosso uso de cookies. Política de privacidade
Aceitar